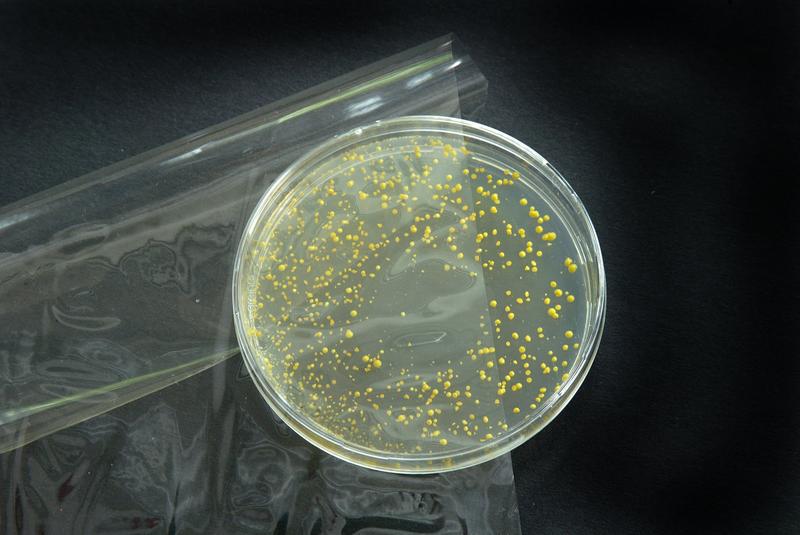
Diese Folie auf Lackbasis gibt einen antimikrobiellen Wirkstoff an die Produktoberfläche ab. Auf diese Weise schützt sie Lebensmittel wie Fleisch, Fisch oder Käse vor Keimen.

Aktive Verpackung hält Fleisch länger frisch
Fleisch bleibt im Supermarkt nur wenige Tage haltbar. Forscher haben eine antimikro-biell aktive Verpackungsfolie entwickelt. Sie tötet die Mikroorganismen ab, die sich auf der Produktoberfläche befinden. Damit lässt sich die Haltbarkeit von Frischfleisch, aber auch von Käse, Fisch oder Schnittwurst verlängern.
Die Qualitätsansprüche der Verbraucher sind hoch: Sie erwarten gebrauchsfertig portionierte Lebensmittel, die tagelang frisch bleiben und ihr gutes Aussehen behalten. Dies gilt insbesondere für Fleisch- und Wurstwaren. Frisch geschlachtetes Fleisch ist fast keimfrei. Allerdings wird es beim Zerlegen und Weiterverarbeiten im Betrieb mit Mikroorganismen kontaminiert, etwa durch Kot an Häuten und Fellen, durch Keime an Werkzeugen, Händen oder Spülwasser. So kommt es, dass das zunächst appetitlich aussehende Frischfleisch im Supermarkt schon nach wenigen Tagen seine Farbe, seine Textur und seinen Geruch ändert. Ausschlaggebend dafür sind chemische, physikalische und mikrobiologische Prozesse, etwa die Bildung von biogenen Aminen. Sie werden unter anderem durch das Wachstum der auf dem Fleisch befindlichen Mikroorganismen verursacht. Rund 20 verschiedene Bakteriengattungen, Hefen und Schimmelpilze spielen dabei eine Rolle.
Neuerdings bieten antimikrobiell aktive Verpackungen eine Möglichkeit, die Qualität und Sicherheit des Produkts über einen längeren Zeitraum aufrechtzuerhalten. Laut EU-Verordnung 450/2009 können sie die Haltbarkeit eines verpackten Lebensmittels verlängern. Sie dürfen gezielt Bestandteile enthalten, welche Stoffe an das verpackte Lebensmittel abgeben können. Bisher gibt es solche Folien in Japan. Dort kommen als aktive Wirkstoffe unter anderem Silber, Wasabi und Ethanol zum Einsatz.
Die Lebensmittelchemikerin Carolin Hauser vom Fraunhofer-Institut für Verfahrenstechnik und Verpackung IVV in Freising hat nun eine neue antimikrobiell aktive Folie auf Lackbasis entwickelt und getestet. Die Folie funktioniert nach dem Release-Mechanismus. »Das bedeutet, dass ein antimikrobieller Wirkstoff bei direktem Kontakt an die Produktoberfläche abgegeben wird«, sagt Hauser. »So bietet die Verpackung mit nur geringsten Mengen dieses Wirkstoffs einen effektiven Schutz des Fleisches. Denn gerade dessen Oberfläche stellt den primären Angriffspunkt für die Keime dar.« Natürlich kommen für solche Folien nur Wirkstoffe in Frage, die den lebensmittelrechtlichen Vorschriften entsprechen, nicht giftig oder allergen sind, dazu neutral riechen und schmecken. Außerdem muss sich der Wirkstoff gut auf die Folien aufbringen lassen. Aus all diesen Gründen wählte Carolin Hauser Sorbinsäure. Die Säure wird in einem Lack gelöst und auf eine Basisfolie aufgetragen.
Für die Tests hat die Forscherin Stücke aus einem Schweinelachs entnommen und einen Tag nach der Schlachtung mit jeweils rund 1000 koloniebildenden Einheiten des pathogenen Keims von E.coli kontaminiert. Anschließend wurden die Stücke in normale und aktive Folie verpackt. Nach sieben Tagen Lagerung im Kühlschrank bei acht Grad Celsius zeigten sich schon starke Unterschiede in der Farbe. Auch die mikrobielle Untersuchung ergab, dass die Keime durch die Folie erfolgreich abgetötet wurden. So fiel die Anzahl der E.coli-Bakterien innerhalb von sieben Tagen auf etwa ein Viertel des Anfangswertes. »Die Gesamtkeimzahl auf der Oberfläche reduzierte sich nach einer Woche im Vergleich zu der unbehandelten Folie deutlich«, sagt die Lebensmittelchemikerin. »Dies lässt darauf schließen, dass sich unsere aktive Folie auch für den Erhalt der Frische und vor allem für die Sicherheit von Fleischzubereitungen, Käse, Fischfilets und Schnittwurst eignet.«
Weitere Informationen:
http://www.fraunhofer.de/presse/presseinformationen/2010/10/antimikrobielle-verpackung-folie.jsp Ansprechpartner
Ähnliche Pressemitteilungen im idw